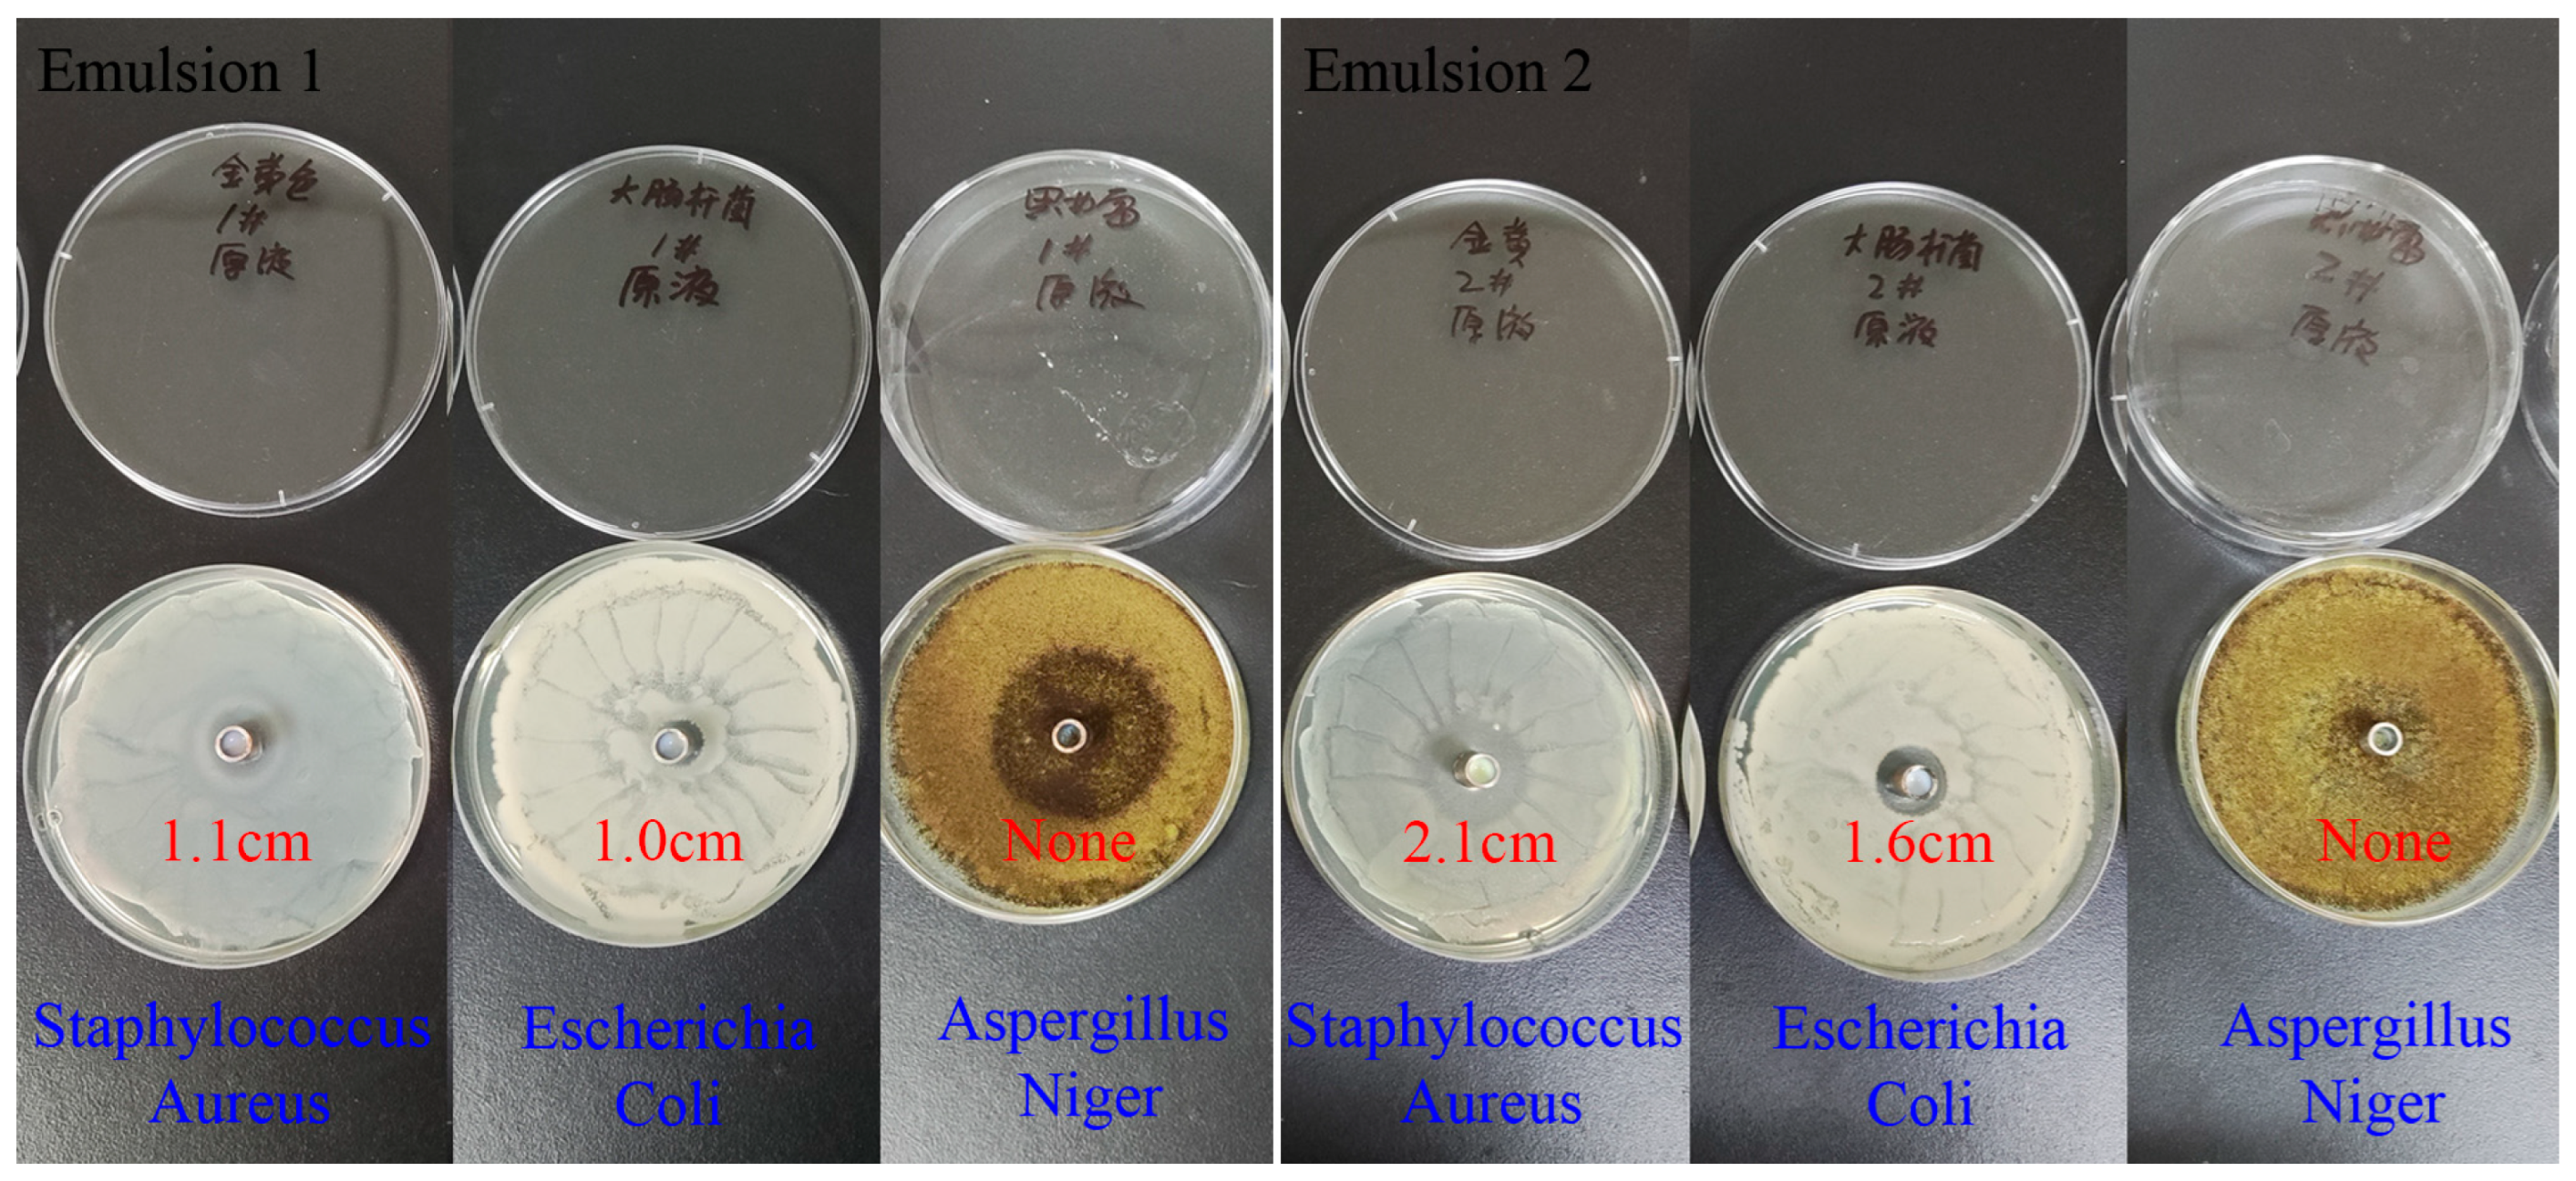
Surfaces 07 00055 g006

Synthesis and Properties of Novel Acrylic Fluorinated Surfactants
Abstract
1. Introduction
2. Materials and Methods
3. Results and Discussion
3.1. Surface Activities
3.2. Foaming Properties
3.3. Coating Applications
4. Conclusions
Supplementary Materials
Author Contributions
Funding
Institutional Review Board Statement
Data Availability Statement
Conflicts of Interest
References
- Simons, J.H. Electrochemical Process of Making Fluorine-Containing Carbon Compounds. US2519983A, 22 August 1950. [Google Scholar]
- Chen, Y.; Petkov, J.T.; Ma, K.; Li, P.; Webster, J.R.; Penfold, J.; Thomas, R.K.; Allgaier, J.; Dalgliesh, R.; Smith, G. Manipulating the hydrophilic/hydrophobic balance in novel cationic surfactants by ethoxylation: The impact on adsorption and self-assembly. J. Colloid Interface Sci. 2024, 674, 405–415. [Google Scholar] [CrossRef] [PubMed]
- da Silva, M.d.G.C.; da Silva, M.E.P.; de Medeiros, A.O.; Meira, H.M.; Sarubbo, L.A. Surface Properties and Biological Activities on Bacteria Cells by Biobased Surfactants for Antifouling Applications. Surfaces 2022, 5, 383–394. [Google Scholar] [CrossRef]
- Drakesmith, F.; Hughes, D. The electrochemical fluorination of octanoyl chloride. J. Appl. Electrochem. 1979, 9, 685–697. [Google Scholar] [CrossRef]
- Haszeldine, R. Synthesis of fluorocarbons, perfluoroalkyl iodides, bromides and chlorides, and perfluoroalkyl grignard reagents. Nature 1951, 167, 139–140. [Google Scholar] [CrossRef] [PubMed]
- Hutchinson, J. The chemistry and properties of a new range of fluorochemical surface active agents. Eur. J. Lipid Sci. Technol. 1974, 76, 158–163. [Google Scholar] [CrossRef]
- Murphy, P.M.; Baldwin, C.S.; Buck, R.C. Syntheses utilizing n-perfluoroalkyl iodides [RFI, CnF2n+1-I] 2000–2010. J. Fluor. Chem. 2012, 138, 3–23. [Google Scholar] [CrossRef]
- Ng, C.A.; Hungerbuehler, K. Exploring the Use of Molecular Docking to Identify Bioaccumulative Perfluorinated Alkyl Acids (PFAAs). Environ. Sci. Technol. 2015, 49, 12306–12314. [Google Scholar] [CrossRef]
- Renner, R. The long and the short of perfluorinated replacements. Environ. Sci. Technol. 2006, 40, 12–13. [Google Scholar] [CrossRef]
- Venkatesan, A.K.; Halden, R.U. Loss and in situ production of perfluoroalkyl chemicals in outdoor biosolids–soil mesocosms. Environ. Res. 2014, 132, 321–327. [Google Scholar] [CrossRef]
- Vierke, L.; Möller, A.; Klitzke, S. Transport of perfluoroalkyl acids in a water-saturated sediment column investigated under near-natural conditions. Environ. Pollut. 2014, 186, 7–13. [Google Scholar] [CrossRef]
- Lu, Y.; Gao, K.; Li, X.; Tang, Z.; Xiang, L.; Zhao, H.; Fu, J.; Wang, L.; Zhu, N.; Cai, Z.; et al. Mass Spectrometry-Based Metabolomics Reveals Occupational Exposure to Per- and Polyfluoroalkyl Substances Relates to Oxidative Stress, Fatty Acid β-Oxidation Disorder, and Kidney Injury in a Manufactory in China. Environ. Sci. Technol. 2019, 53, 9800–9809. [Google Scholar] [CrossRef] [PubMed]
- Zhong, H.; Liu, W.; Li, N.; Ma, D.; Zhao, C.; Li, J.; Wang, Y.; Jiang, G. Assessment of perfluorohexane sulfonic acid (PFHxS)-related compounds degradation potential: Computational and experimental approaches. J. Hazard. Mater. 2022, 436, 129240. [Google Scholar] [CrossRef]
- Lin, C.; Pan, R.; Xing, P.; Jiang, B. Synthesis and combined properties of novel fluorinated cationic surfactants derived from hexafluoropropylene dimer. Chin. Chem. Lett. 2018, 29, 1613–1616. [Google Scholar] [CrossRef]
- Sha, M.; Pan, R.; Xing, P.; Jiang, B. Synthesis and surface activity study of branched fluorinated cationic (FCS), gemini (FGS) and amphoteric (FAS) surfactants with CF3CF2CF2C(CF3)2 group. J. Fluor. Chem. 2015, 169, 61–65. [Google Scholar] [CrossRef]
- Zhang, D.; Sha, M.; Pan, R.; Lin, X.; Xing, P.; Jiang, B. Design and synthesis of the novel branched fluorinated surfactant intermediates with CF3CF2CF2C(CF3)2 group. Chin. Chem. Lett. 2019, 30, 566–568. [Google Scholar] [CrossRef]
- Kostov, G.; Boschet, F.; Ameduri, B. Original fluorinated surfactants potentially non-bioaccumulable. J. Fluor. Chem. 2009, 130, 1192–1199. [Google Scholar] [CrossRef]
- Zhang, Q.; Luo, Z.; Curran, D.P. Separation of “light fluorous” reagents and catalysts by fluorous solid-phase extraction: Synthesis and study of a family of triarylphosphines bearing linear and branched fluorous tags. J. Org. Chem. 2000, 65, 8866–8873. [Google Scholar] [CrossRef]
- Holt, D.J.; Payne, R.J.; Chow, W.Y.; Abell, C. Fluorosurfactants for microdroplets: Interfacial tension analysis. J. Colloid Interface Sci. 2010, 350, 205–211. [Google Scholar] [CrossRef] [PubMed]
- Ngo, T.H.V.; Damas, C.; Naejus, R.; Coudert, R. A comparative study of micellization with fluorinated and hydrogenated diquaternary ammonium bolaamphiphiles. J. Colloid Interface Sci. 2013, 400, 59–66. [Google Scholar] [CrossRef]
- Xiao, J.; Gao, Z.; Wang, M.; Cui, R. Laboratory method for evaluating the performance of aqueous film-forming foam fire-extinguishing agent. Chem. Res. Appl. 2008, 20, 569–572. [Google Scholar]
- Zhou, J.; Chen, X.; Duan, H.; Ma, J. Synthesis and characterization of organic fluorine and nano-SiO2 modified polyacrylate emulsifier-free latex. Prog. Org. Coat. 2015, 89, 192–198. [Google Scholar] [CrossRef]
- Li, B.; Li, Y.; Zhao, Y.; Sun, L. Shape-controlled synthesis of Cu2O nano/microcrystals and their antibacterial activity. J. Phys. Chem. Solids 2013, 74, 1842–1847. [Google Scholar] [CrossRef]
- Cooper, K. The theory of antibiotic inhibition zones. In Analytical microbiology; Elsevier: Amsterdam, The Netherlands, 1963; pp. 1–86. [Google Scholar]

| Entry | Systems | CMC (mol/L) | γCMC (mN/m) | ACMC (Å2/mol) |
|---|---|---|---|---|
| 1 | FIS | 6.57 × 10−4 | 23.24 | 2.46 |
| 2 | FBS | 1.15 × 10−3 | 19.02 | 1.65 |
| 3 a | FCS | 2.50 × 10−3 | 19.68 | 52 |
| 4 a | FAS | 1.04 × 10−4 | 21.39 | 35 |
| 5 b | FO1 | 1.73 × 10−2 | 19.93 | 49 |
| 6 b | FO2 | 9.97 × 10−5 | 19.31 | 27 |
Disclaimer/Publisher’s Note: The statements, opinions and data contained in all publications are solely those of the individual author(s) and contributor(s) and not of MDPI and/or the editor(s). MDPI and/or the editor(s) disclaim responsibility for any injury to people or property resulting from any ideas, methods, instructions or products referred to in the content. |
© 2024 by the authors. Licensee MDPI, Basel, Switzerland. This article is an open access article distributed under the terms and conditions of the Creative Commons Attribution (CC BY) license (https://creativecommons.org/licenses/by/4.0/).
Share and Cite
Lin, C.; Li, J.; Qin, Y.; Xing, P.; Jiang, B. Synthesis and Properties of Novel Acrylic Fluorinated Surfactants. Surfaces 2024, 7, 838-845. https://doi.org/10.3390/surfaces7040055
Lin C, Li J, Qin Y, Xing P, Jiang B. Synthesis and Properties of Novel Acrylic Fluorinated Surfactants. Surfaces. 2024; 7(4):838-845. https://doi.org/10.3390/surfaces7040055
Chicago/Turabian StyleLin, Chao, Jinhua Li, Yejun Qin, Ping Xing, and Biao Jiang. 2024. "Synthesis and Properties of Novel Acrylic Fluorinated Surfactants" Surfaces 7, no. 4: 838-845. https://doi.org/10.3390/surfaces7040055
APA StyleLin, C., Li, J., Qin, Y., Xing, P., & Jiang, B. (2024). Synthesis and Properties of Novel Acrylic Fluorinated Surfactants. Surfaces, 7(4), 838-845. https://doi.org/10.3390/surfaces7040055

